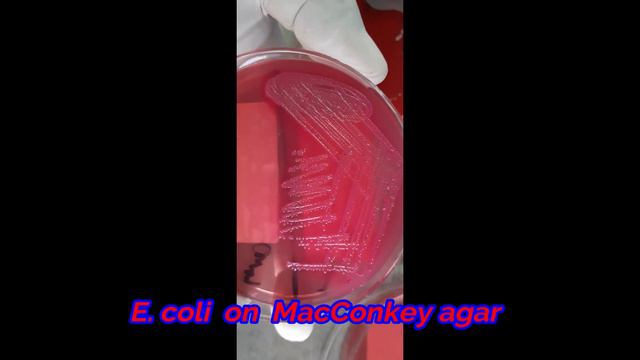
Staphylococcus Aureus , E  Coli And Klebsiella Penumoniae On Growth On Various Media

Тайные истории
- ⌚ 20.04.2024 70歲老廚師教我做西紅柿雞蛋湯,做法簡單,味道真的不一般【劉姐廚房 Magic Food】#西紅柿雞蛋湯
- ⌚ 20.04.2024 Mod на Singularity Slimes для Slime Rancher
- ⌚ 20.04.2024 По просьбам трудящихся. Пчелопавильон. 2ч. Хакасия.
- ⌚ 20.04.2024 SLS Cancun Hotel & Spa, Cancún, Mexico
- ⌚ 20.04.2024 My Clematis (ALIEN STAGE) || VIVINOS || Sub. Español
- ⌚ 20.04.2024 Общегородской турнир OLE в формате 8х8. XII сезон. ВМедА-2 - Аптека Фиалка
- ⌚ 20.04.2024 ♡: Пряный имбирь, ขิงก็ราข่าก็แรง, Khingkorrarkharkorrang
- ⌚ 20.04.2024 SWATCHFEST: 3ce Velvet Lip Tints | Beauty By Tellie
- ⌚ 20.04.2024 Harvesting Sour Oranges! The Best Flavoring For Foods ☆ Persian Cuisine
- ⌚ 20.04.2024 Чайф(Кавер)-Жизнь в розовом дыму.AVI
- ⌚ 20.04.2024 Dijual - TANAH Kavling Cluster Casa Tobago, Grand Island Pakuwon City, Surabaya | TAGS Properti
- ⌚ 20.04.2024 7 Days To Die - Darkness Falls (DAY 2) Finding A Home
- ⌚ 20.04.2024 Рандом│Сделал дело - дело сделано│Crossout
- ⌚ 20.04.2024 Честер - зимовка в открытом грунте. Январь 2021.
- ⌚ 20.04.2024 Mirt Video Axira Geder Baxin
- ⌚ 20.04.2024 Колеусы в июне.беру черенки.
- ⌚ 20.04.2024 БЕЗ ЭТОЙ ОБРАБОТКИ МАЛИНА НЕ ДАСТ ХОРОШИЙ УРОЖАЙ. #малина#весенняя#обработка#хорошийурожай
- ⌚ 20.04.2024 PINKY NANI NKA ATMA KAHANI@ KHANTI RAYAGADIA
- ⌚ 20.04.2024 Staphylococcus Aureus , E Coli And Klebsiella Penumoniae On Growth On Various Media
- ⌚ 20.04.2024 ОН ЖИВЕТ В БАНКЕ